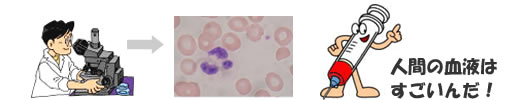

生化学検査
血液の中に含まれる化学物質、酵素などを各種の自動分析装置で測定します。
結果の組み合わせにより肝臓、腎臓、すい臓などの各臓器の状態がわかります。また、糖尿病や高脂血症など生活習慣病の診断にも役立ちます。
血液検査
血液の中に含まれる赤血球などの血球成分や、血液の止まり具合をみる凝固因子を測定します。貧血や炎症の有無、出血しやすいかなどがわかります。
顕微鏡で血液を見てみると・・
一般検査
一般検査には、尿、糞便、穿刺液(胸水・腹水・関節液)検査があります。
尿検査は、尿中のタンパク・糖・潜血等の検査を行い、必要があれば尿中の細胞成分を調べます。
糞便検査は、寄生虫やその卵の検査と消化管(胃・腸など)からの出血の有無を調べます。
胸水・腹水については、その性状や細胞成分を調べます。
関節液については、その性状や結晶等を調べます。
細菌検査
 微生物は、細菌、酵母、カビ、クラミジア、ウイルスなどに大きく分けられます。
微生物は、細菌、酵母、カビ、クラミジア、ウイルスなどに大きく分けられます。
細菌検査は、これらのうち人体に病害作用をあたえる原因微生物を同定または推定し(例えばサルモネラ菌、病原性大腸菌O-157、肺炎球菌、結核菌、インフルエンザウイルスなど)、最も適した抗菌薬を選択して化学療法の手助けを行う検査です。
生理検査
生理検査とは、患者様に直接検査機器をあて、生理機能を測定する検査です。ここでの検査は、大部分が痛みを伴いません。













